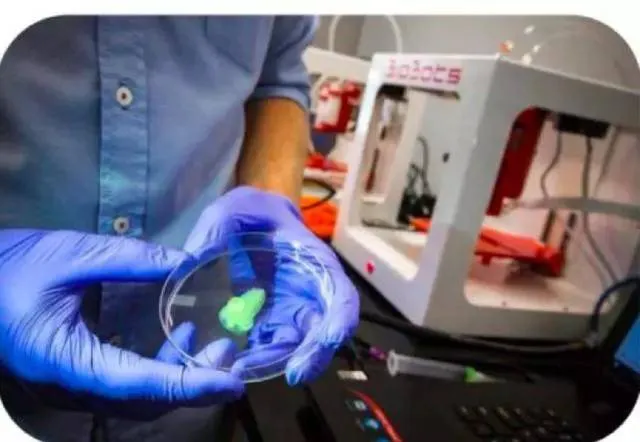

医疗健康行业的趋势

根据CB INSIGHTS,目前热点的舆情走势
1、数字医疗的趋势
根据CB insights数据库,自2013年以来,数字医疗领域的股权融资额累计高达280亿元,共达成交易4,412次。
报告认为,未来数字医疗将呈现三大趋势,第一大趋势是利用AI设计药物;第二大趋势是利用可穿戴设备让药物输入和监测更智能;第三大趋势是利用区块链以实现全球医疗数据共享。而推动这些趋势不断加速演变的过程中,创业公司的力量不可忽视,甚至其对整个医疗健康行业的影响力正在逐步扩大。
趋势一:AI在新药研发中的新角色
大数据时代,超级计算机促进了合理药物设计研发,这种药物研究模式的转变推动了创新新药发现又一个春天的到来。科研信息化基础设施的升级,包括高性能计算机处理器技术的不断更新,新的资源模式的出现,使得超算技术与计算生物学、计算化学密切结合,进一步为传统的药物发现和计算机辅助药物设计增添了新功能,加速了分子动力学模拟和虚拟筛选等的研究进程。这可以缩短药物发现时间、提高结果质量、以及大量节省成本。

以往的药物发现方法需要6年时间左右

AI可以大幅缩短药物的发现时间
BenevolentAI:利用人工智能发现了新的ALS治疗药物

BenevolentAI坐落于有知识街区之称伦敦国王十字区,该公司主要是利用人工智能技术,从散乱无章的海量信息中,提取出能够推动药物研发的知识和新的可以被验证的假说,从而加速药物研发的过程。创始人Ken Mulvany 称,公司在早期临床发展方面有二十余个项目,如ALS(肌萎缩性脊髓侧索硬化症)。此外,还有3-4个二期项目,其中一项涉及了bavisant在治疗帕金森患者的睡眠问题时的疗效。涉及总融资额1.406亿美元(估值约10亿美元)。
Atomwise:用AI研发新药,成本猛减数亿美金

Atomwise公司成立于2012年6月,是一家利用超级计算机进行药品研发的公司。项目旨在运用超级计算机、AI和复杂的算法模拟制药过程,来预测新药品的效果,同时降低研发成本。公司总部位于美国旧金山。目前,它正在与27家研究机构和公司合作,包括了斯坦福大学、IBM和默沙东等机构在内。公司CEO Levy博士表示,Atomwise正在进行一项计划,有可能会筛选多达1,000万个分子,以及找到科学家个人需求的六十余种最佳化合物。至今公司涉及融资总额为612万美元。
TwoXAR:AI驱动研究新型类风湿关节炎药物

TwoXAR位于加州帕罗奥图,是一家AI导向的生物制药公司。TwoXAR采用电子系统对数千种药物进行检测,以期发现药物和疾病之间一些未知的联系。TwoXAR宣布已经在类风湿关节炎,肝癌和2型糖尿病等疾病的前期临床实验中取得了积极进展。涉及融资总额为340万美元。
趋势二:“以皮肤为平台,让一切变得可穿戴”
即将可穿戴装备放置在皮肤上以进行持续的生理监测和药物输送。现行的监测手段,如量血压和测心率等都是不规律的并且容易有人为失误;而目前的药物输送手段,不管是输液还是药片,也同样容易会有失误。以皮肤为平台能让患者更自由地安排时间。比如穿戴式的生物识别监测器能直接接触皮肤以确保持续性监测。这类监测器的好处很多,例如能减少患者住院时间;减少健康护理所需要的工作量;数据更可靠,降低人为失误等等。
ChronoTherapeutics:戒烟可穿戴设备

位于加州的海沃德,公司研发了一种穿戴式药贴片从而实现了透皮给药。与贴片配套的平台会对时间和剂量进行管理。该公司的第一款产品是一个为期十周的尼古丁替代程序。同时公司也在研究帕金森,阿片类药物戒烟和慢性疼痛的治疗方法。涉及融资总额8,470万美元。
Vital Connect:一次性可穿戴人体传感器,减轻护士压力

2011年创立于美国硅谷,公司为远程患者检测研发的一款生物识别感应设备已获得FDA批准。这一设备能测量出单导联心电图、心率,呼吸频率和皮肤温度等。Vital Connect还和美国布列根和妇女医院和退伍军人管理医院合作进行试验。已完成两轮融资,涉及融资总额8,440万美元。
Sano Intelligence:非入侵式血液检测技术

Sano Intelligence是来自旧金山的一家初创公司,于2012年创立。该公司发明出佩戴式感应垫,可持续监测人体血液生化指标。这种传感器皮肤贴片,采用的是无针技术,贴在皮肤上无痛感,可监控你的基本代谢状况,如血糖水平、肾脏功能、电解质平衡等等。涉及融资总额达到1,003万美元。
趋势三:区块链在医疗数据方面的应用
报告认为,医疗数据的现状处于孤立、易受袭击的、分散式;而医疗数据的未来,则应该是集中的、受保护的、网络式。实现这一目标,区块链的作用不可忽视。

下面是区块链在医疗数据方面的四大应用方向
数据安全:登记在区块链上的医疗数据会被加密处理;患者可以选择更有保障的途径,例如医疗健康提供者。
供应链:一个幕后的区块链网络系统可以确保供应流程每一个环节的质量把控,从制造商到医疗人员再到患者。
医疗记录共享:不同于将患者的信息孤立地存储在当地的医院,患者的每一次新的就诊经历都会被记录在一个公共平台上,这些信息的获取权限由患者本人控制。
报销:由于区块链能够确认就医过程的每一个环节,保险公司的报销会变得相对容易。
Patientory:区块链医疗应用平台

位于亚特兰大的Patientory 正在建立一个全球健康信息互换系统以实现全球医疗数据共享。该公司成立于2015年并计划开发一款针对患者的APP。患者可以使用该公司提供的电子货币在该平台上存储个人健康信息。目前融资总额为722万美元。
Gem:区块链API提供商

位于加州的Gem目前专注于研发医疗健康的区块链应用和供应链管理。该公司研发的“Gem Healthcare Network”能提高区块链的安全系数:在该平台患者的每次就诊经历都会被记录,同时这些数据的权限由患者自己掌控。这家加州创业公司至今共计融得资金1,040万美元。
Chronicled:区块链监测供应链与药品包装

一家成立于2014年位于加利福尼亚的创业公司,公司研发了有特殊用途的区块链应用,这些应用涉及了供应链以及IoT。其中一项应用是通过智能感应设备来识别并记录药物,血液和器官的温度。Chronicled今年还与咨询团队LinkLab联手研发了MediLiegerProject,以期用区块链为制药业提供新的解决方式。至今共计融得资金483万美元。
2、生物技术的趋势
趋势一:CAR-T治疗
CAR-T全称是Chimeric Antigen Receptor T-Cell Immunotherapy,嵌合抗原受体T细胞免疫疗法,被认为是最有前景的肿瘤治疗方式之一。原理使用个体患者自己的T细胞产生的定制化治疗。患者的T细胞被收集并送到制备中心,在那里进行遗传修饰(嵌合抗原受体或CAR的新基因表达),其指导T细胞靶向并杀死具有表面上的特异性抗原(CD19)。一旦细胞被修饰,在它们被注入到患者体内时可以杀死癌细胞。直到最近FDA批准的第一个CAR-T药物Kymriah,在美国被应用于治疗3-25岁的难治性或复发性的急性B淋巴细胞白血病(ALL)患者。

CAR-T是基因组学、细胞工程学和免疫学的融合
这个领域才刚刚起步
Autolus:新一代细胞疗法,有效解决肿瘤逃逸问题

作为从伦敦大学学院剥离而出的生物技术公司,Autolus希望开发出比如今处于申请阶段的CAR-T疗法更安全有效的新一代疗法用于治疗血液瘤以及实体瘤。最近,Autolus颁布发表在其针对MM(多发性骨髓瘤)的首例两重靶向CAR-T细胞疗法已完成了I期/ II期临床试验中的第一剂量行列研讨。目前这家公司已经融资约1.857亿美元。
科济生物(CARSGEN):CAR-T治疗实体瘤

专注于开发基于CAR-T自体免疫疗法治疗实体瘤的上海科济生物医药,近期在美国临床肿瘤协会(ASCO))2017年会上公布了全球首个针对GPC3靶点的、使用CAR-T细胞治疗难治复发的肝细胞癌的一期临床试验结果。公司期望到2017年第二季度完成anti-EGFR和anti-GPC3项目的临床前测试,并向FDA提出IND申请。涉及总融资额达到3,000万美元。
此外还有TILT Biotherapeutics、Vira therapeutics等布局CAR-T、TCR-T疗法的企业。
趋势二:RNA疗法
过去RNA一直被当成细胞裡的灰姑娘,执行细胞裡的基本工作,如今却成为未来医学深具治疗潜力的新星。从癌症到自身免疫疾病,蛋白质表达过度/过少是主要的原因,但是从医学上很难调控。RNA与蛋白质形成有关,针对RNA的疗法有可能阻止疾病。RNA-Base疗法,RNAi通过沉默或关闭基因来起作用。90年代首次在植物中发现RNAi,并称为“基因沉默”,2001年有研究表明哺乳动物细胞也有类似的机制。

Moderna Therapeutics:利用RNA-based疫苗防御ZIKA病毒

Moderna Therapeutics是位于马萨诸塞州剑桥市的生物科技初创公司,Moderna的mRNA体内表达技术是在受体细胞中直接导入病毒的mRNA,利用受体细胞的核糖体蛋白合成系统直接合成蛋白,然后刺激免疫系统产生抗体,使机体获得对某种病毒的抵抗力。关于寨卡疫苗,公司发言人Liz Melone表示,“在动物试验中寨卡疫苗已经产生了强烈的免疫反应。” 目前,Moderna的mRNA 1440疫苗(针对的传染病对外保密)已经在欧州开始了临床I期试验,结果预计于2017年揭晓。至今公司的融资总额达到13.4亿美元。
Translate Bio:利用RNA治疗囊肿纤维化(CF)

Translate Bio前身是RaNA Therapeutis,利用RNA疗法治疗基因表达失调,该公司开发出新型的mRNA,用于体内产物包括细胞内、细胞膜相关和分泌蛋白。其针对囊肿纤维化和鸟氨酸转氨嫁酰酶缺乏症的项目有望最早在2018年进入临床I期试验。公司涉及融资总额为1,505万美元。
Arrakis:RNA靶向药物开发

Arrakis Therapeutics是一家致力于研发RNA靶向小分子药物的生物制药初创公司,专注于神经内科、癌症以及罕见遗传性疾病的治疗。公司于2月27日宣布获得了3800万美元A轮融资,将用于开发旗下两个专有的发现平台Tryst和Pearl-Seq。
趋势三:抗衰老治疗
100%的动物会变老,但是衰老的生物机理还没有完全弄清楚。不确定的衰老机理使得抗衰老治疗开发受阻。目前衰老的机制主要有四点,分别是细胞衰老、自由基、端粒酶和DNA甲基化学说。初创企业利用近期生物机制和基因组学的进步,开发出创新的抗衰老治疗方法。
Unity:选择性清除衰老细胞

Unity Biotechnology 是一家私有生物技术公司,致力于预防、治疗和改善由于衰老而产生的老年疾病。通过清除衰老细胞,可以治疗由细胞衰老引起的疾病,例如关节炎、动脉硬化、视力下降、肾脏疾病等。UNITY由业界着名风投ARCH Venture Partners和Venrock支持,其国际顶尖的管理团队拥有丰富的创业和药物开发经验,团队共开发过91个进入临床试验的药物,其中13个获得FDA批准。至今公司的融资总额达到1.513亿美元。
3、医疗器械的趋势
趋势一:生物打印
人体器官资源非常匮乏,所以器官移植非常昂贵。据统计在美国器官移植的平均治疗费用为,心脏140万美元、肠110万美元、骨髓89.3万美元、肺86.2万美元、肝脏81.3万美元、肾脏41.5万美元、胰腺34.7万美元、角膜3万美元。所有器官的平均等待时间超过了1年。而3D生物打印技术的进步将会使得器官移植无限制,更经济。

美国器官移植的平均治疗费用

所有器官的平均等待时间超过了1年
Prellis Biologics:3D打印分泌胰岛素的胰岛

旧金山人体组织工程公司PrellisBiologics使用3D打印技术开发出一种新方法来制造可行的人体器官。相比其他3D生物打印技术,公司能3D打印出为细胞提供营养和氧气的复杂微血管系统。该公司的最终目标是3D打印任何类型的人体器官和组织,以用于药物研发和移植。Prellis表示“首批3D打印组织将是分泌胰岛素的胰岛” ,并已着手研发具有免疫反应和能产生抗体的淋巴器官的打印。公司近期获180万美元种子轮投资。
BioBots:3D生物打印机中的PC
3D打印公司Biobot为活体组织的制造研发硬件、软件、试剂。公司的旗舰产品是Biobot2,精确度可达亚微米级。这一产品主打实用性和经济性,每台仅售4万美元;产品体积较小可放置在桌面上。
Aspect Biosystems:开发3D打印半月板软骨

加拿大生物技术公司Aspect Biosystems 则为3D组织定制研发硬件和软件。公司的核心技术是Lab-on-a-Printers。目前公司已与Johnson&Johnson合作开发半月板的生物打印。
趋势二:可植入设备辅助神经外科治疗
长久以来,医学的发展因为无法与神经系统很好互动而受到一定限制。
过去,医学对解剖神经学的理解匮乏,缺少记录大脑活动的神经监测系统,导致无法将特定的疾病和大脑的某些部位联系起来。现在,医学对解剖神经学有大致的了解但对某些细节认识不清,不过已经能确定大脑的某些发病区域并运用一些辅助设备进行治疗,相当于神经系统开始被延伸到身体之外。
报告认为,未来大脑和机器的双向交流将成为常规;在神经系统疾病(比如癫痫)的治疗中一些软件有可能会取代药物;电脑将成为人类思维的外延。
Kernel:植入式神经元装置只是个开始
怀揣助力人工智能发展的宏愿,千万富翁Bryan Johnson创立了Kernel。利用纽约大学、麻省理工、哥伦比亚大学和西北大学的研究成果,公司自己研发了治疗神经系统疾病(例如癫痫,痴呆和阿尔茨海默病)的软件和硬件。Kernel还计划使用类似于所显示的植入式神经元装置启动临床试验,以测试这项装置能否使老鼠恢复或改善记忆功能。Kernel目前已获得1亿美元融资。
G-Therapeutics:可植入脊髓辅助设备

G-Therapeutics研发了一款可植入脊髓辅助设备来帮助脊髓受损的患者。完整的治疗方案既包括可植入脊髓辅助设备,也包含了物理锻炼。G-Therapeutics目前正开展临床实验对这一设备在慢性不完全脊髓受损患者的治疗效果展开评估。目前公司融资总额达到4,008万美元。
Synchron:利用辅助技术实现直接的大脑控制

公司正在研发一款名为Stentrode系统的可植入设备以帮助瘫痪病人实现对移动辅助设备的直接大脑控制。Stentrode系统是一个小型设备穿越颅内血管定位在大脑里,以识别神经元释放的电子信号。公司正着手进行早期临床实验以检测该设备的安全性和可行性。
趋势三:手持式诊断设备
报告显示,数百万患者因缺乏廉价的移动诊断技术而未得到治疗。Khosla Ventures 创始人Vinod Khosla表示:“因为软件的发展,诊断正变得越来越便捷并有了更大规模的应用。”
QuantuMDx

QuantuMDx公司研发出了手提式分子诊断设备。公司的旗舰产品Q-POC为患者的诊断和药物过敏测试提供DNA排序,并且能在10-20分钟内完成。QuantuMDx正在研究开发可以测试华法林代谢、性传播感染、疟疾的应用,还与比尔和梅琳达·盖茨基金会合作进行结核病和宫颈癌的检测。这一诊断设备预计将于2018年实现商业化。
Two-poreGuys

总部设在加利福尼亚州圣克鲁斯市的Two-poreGuys’(2PG)公司研发的手持测试系统与血糖监测仪的工作原理类似,不过它的一次性检测剂几乎能检测出所有的分子并且具有极高的灵敏度。该系统成为首个在检查结肠直肠癌和胰腺癌的液体活检中使用的系统。在传统实验室进行的测试同样适用于2PG平台,这为其开发出更多的测试系统提供了无限可能。2017年,2PG成为第一个将手持检测系统应用于结肠直肠癌和胰腺癌液体活检的公司。
Basli Leaf Technologies

Basli Leaf Technologies是2017年高通三录仪X PRIZE竞赛的获奖者,在一款名为DxtER的AI产品的基础上公司研发出了一款手持检测设备。他们的主要产品是一款检测血糖、白细胞和血红蛋白的非侵入性监测仪。该设备目前还处于第一阶段临床实验。公司正在研发数字听筒对肺炎和哮喘进行辅助检查。
数据来源:CB Insights, Healthcare Horizons, Starups and technologies poised to have the greatest impact on healthcare, 2017
编译整理:广东医谷研究员赖志城
本文为广东医谷原创编译文章,转载请标明来源和作者。
如有侵权,请联系后台删除。谢谢。
广东医谷南沙园区招商火热进行中!
招商热线:020-8998 3456
想要参与开放日项目路演的团队可发送您的项目bp至邮箱:bp@gdmv.cn



